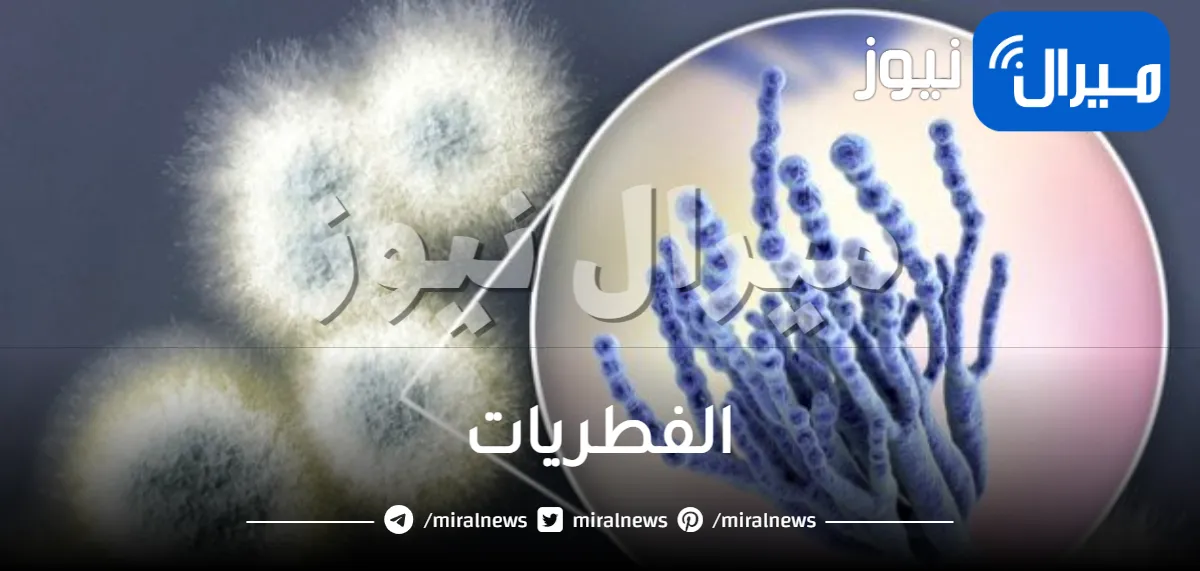
الفطريات

الفطريات هي كائنات حية لا يكون لدينا مادة الكلوروفيل المستخدمة في صناعة الغذاء، كذلك بالإضافة إلى أنها لا تستطيع أن تقم بإنتاج الغذاء بذاتها.
ماهي الفطريات
إن الفطريات هي كائنات حية غير ممتلكة لمادة الكلوروفيل التي يتم استخدامها في صناعة الغذاء.
- كذلك لا يوجد لها مقدرة على إنتاج الغذاء بنفسها، حيث أنها تتغذى من البيئة المحيطة بها.
- كما أن العلماء قالوا أنه يوجد أكثر من ما يقرب من حوالي 100 ألف نوع مختلف من الفطريات.
- كذلك أن بعضها يحتاج إلى رؤيه مجهرية، والبعض الآخر يتم رئته بالعين المجردة.
أنواع الفطريات
هناك أنواع عدة منها، لكن من أبرز هذه الأنواع، كل ما يلي:
الفطريات الخيشومية
- يعد ذلك النوع من بين أنواع الفطريات المعروفة والشائعة، والتي من بينها عش الغراب السام.
- هذا بالإضافة إلى عش الغراب الذي من الممكن أن يتم تناوله، كما أنه يعتمد بغذائه على بقايا الحيوانات والنباتات المتواجدة بالتربة.
فطريات العفن
- في الحقيقة أن ذلك النوع من ضمن الفطريات التي تنمو معظم أنواعها على الأنسجة الميتة.
- كما أنه توجد من أنواعها ما يقم بالعيش بشكل طفيلي.
- بجانب أنه من الممكن أن تؤثر بالأعلاف وتقوم بإتلافها إذا كانت قيمتها ما بين 100 ألف – 320 ألف مستعمرة/غم.
- إذ أنها تؤثر سلباً بالحيوانات وتؤدي إلى حدوث أعراضاً بأجهزته المختلفة، كالجهاز الهضمي والتناسلي، والعصبي والجلدي وكذلك البولي.
فطريات ترايكودرما
- هذا الفطر يقوم بمُكافحة الأمراض النباتية كلها، بجانب أنه يقوم بالمساعدة في علاج أمراض النيماتودا المسببة تعقدات بجذور النباتات.
- إذ أنه من الممكن إضافته لتربة نظيفة مُعقمة وذلك لكي يتم الحصول على أفضل النتائج وأروعها.
فطريات تالاروميسز
- يعيش ذلك النوع مُتطفلاً على فطريات أخرى كفطريات رايزوكتونيا سولاني.
- كما أنه يتم استخدامه كمضاد حيوي بمقاومة بعض أمراض النباتات.
- إذ أنه يحد من تأثير الذبول بالبندورة والبطاطا والباذنجان.
فطريات كونيوثيريام
- ذلك النوع يعيش مُتطفل على فطريات أخرى، وذلك كفطريات سكليروتينيا الموجودة في التربة.
- كما أن هذا النوع يقي ويحمي من الأمراض التي من الممكن أن تقم بإصابة عباد الشمس وذلك عن طريق خلطه مع مجروش الذرة، وبعدها وضعه بالتربة.
خصائص الفطريات
هناك العديد من الخصائص التي تتسم بها الفطريات، حيث أن هذه الخصائص لا حصر لها، إذ أنه من بينها كل ما يلي:
- تعيش في ٣ بيئاتٍ مختلفةٍ كالتربة الرطبة وكذلك الجافة، بجانب المياه العذبة والمالحة، وأيضاً الهواء وتبلغ حتى أعلى المسافات.
- تقم بمهاجمة الإنسان، وتؤدي لحدوث أمراض له كما يحدث حينما تهاجم النباتات والحيوانات، وكذلك مثلما تهاجم الأغذية، وهذا يؤدي لحدوث العفن والتلف.
- هي كائنات غير محتوية على كلوروفيل، حيث أنها لا تقم بإنتاج غذائها بذاتها.
- كما أنها تقوم بالاعتماد على التطفل والترمم، إذ تتكون بعض أنواعها من خلية واحدة فحسب، أي مدمجة الخلية.
- كلم أن البعض الآخر متعددة الخلايا بها غزل فطري، ومن الممكن أن تشتمل جُدُر خلاياها على مادة الكيتين أو مادة السليلوز، بجانب أنها تتكاثر جنسياً ولا جنسياً.
- البعض منها مفيد يقم بالمساهمة في إنتاج الجبن والألبان، كما أن البعض يصلح غذاءً، كعيش الغراب المليئ بالمعادن، والبروتين والكالسيوم، وفيتامين D.
- يتم استخدام بعضها بالعلاجات الطبية، كالبنسلين الذي يقوم فطر البنسليوم بإنتاجه.
- كذلك مثل فطريات الكمأة التي يتم استخدامها في علاج أمراض العيون.
- كذلك فطر الهريسيوم إيريناسيوس ضد السرطان وأيضاً الأورام السرطانية، والفطر النفاث الذي يتم استخدامه في وقف النزيف.
تركيب الفطريات
الفطريات تتكون من جملة كبيرة من النباتات تختلف في أشكالها.
- كما أنها في مجموعها تكون شبيهة بالطحالب لكنها تكون خالية من الكلوروفيل.
- كذلك أن عضها يتكون من خلية واحدة، والمعظم منها عديد الخلايا.
- بجانب أنها تنتظم في خيوط تُسمى باسم الهيفات (المفرد هيفا hupha).
- كما أن مجموع الهيفات التي تكون جسم الفطر تُدعى ميسيليوم.
تكاثر الفطريات
في الحقيقة أن الفطريات تتكاثر بطريقتين، وهما كالتالي:
التكاثر جنسياً
- حيث أن ذلك يحدث من خلال الأبواغ، إذ أن الفكر بإمكانه أن يقم بتكوين نوعين من الأبواغ، ذكرية، وأنثوية.
- كما أن الإخصاب يكون من نوعين مختلفين.
التكاثر لا جنسيّاً
- كما أن هذا للتكاثر يحدث من خلال الانشطار، أو التبرعم مثلما في الخميرة تماماً.
